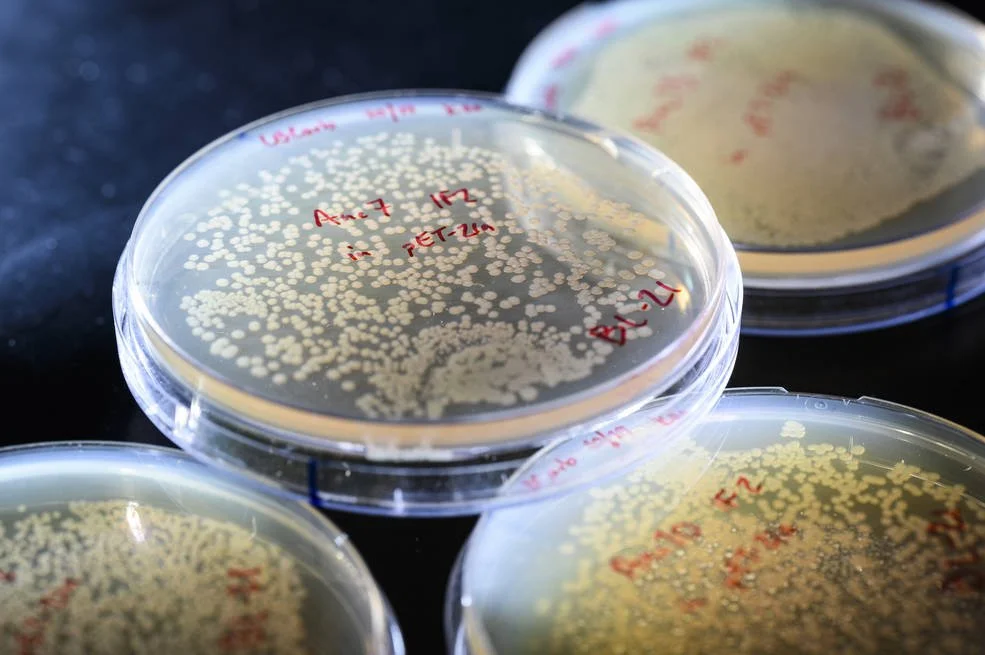
Life RCN unveiled today at AbSciCon 2022

LIFE 2023 Workshop: Nitrogen Cycling Across Planetary Scales
LIFE to kick off the first community workshop to identify outstanding questions and research agenda for N cycles across planetary scales. Speaker details coming soon.
Organizers: Ben Johnson, Iowa State University, USA and Eva Stueeken, St. Andrews College, UK
Read More
Meet the LIFE RCN network!
LIFE is a NASA supported research coordination network focused on understanding early evolution of life and Earth. Meet our steering and early career investigator committees.
Read More
LIFE RCN is featured in Forbes!
Forbes published a great article announcing the launch of LIFE RCN, helping to bring our work to larger and more diverse audiences.
Read More
Life RCN unveiled today at AbSciCon 2022
NASA's Astrobiology program announced its newest Research Coordination Network (RCN) ‘LIFE: Early Cells to Multicellularity”
Read More